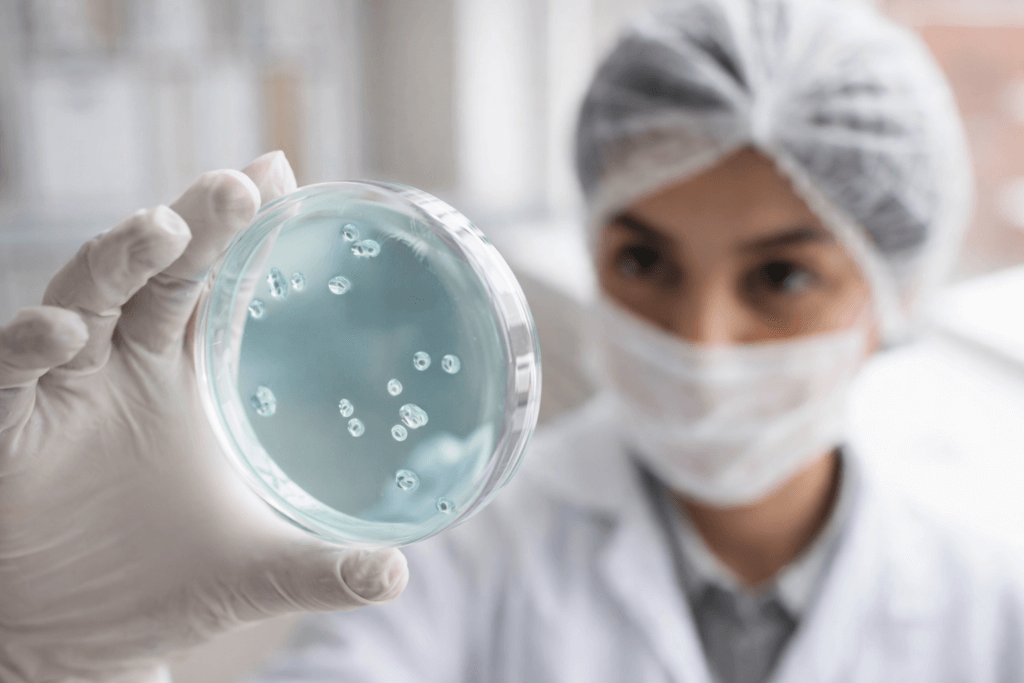

FDA aprova droxidopa para tratamento da hipotensão ortostática neurogênica
Medicamento é liberado sob aprovação acelerada após anos de avaliação regulatória A Food and Drug Administration dos Estados Unidos aprovou a droxidopa para o tratamento da hipotensão ortostática neurogênica, condição rara e incapacitante que afeta pacientes com doenças neurológicas degenerativas. A decisão representa um avanço relevante para pessoas com limitações severas ao permanecer em pé […]